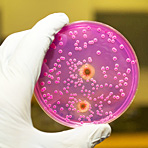

Moderne Lebensweise verändert Darmflora |
Mit dem Leben in Städten und einer zunehmend kosmopolitischen Lebensweise hat sich die menschliche Darmflora dramatisch verändert. Dies berichten US-Forscher nach der Untersuchung von jahrtausendealten Kotproben, sogenannten Koprolithen. Die Bakterien-Zusammensetzung einiger Proben ähnele am ehesten der von heute im ländlichen Afrika lebenden Menschen, schreiben die Forscher im Wissenschaftsjournal «PloS One».
Raul Tito von der amerikanischen Universität von Oklahoma in Norman und seine Mitarbeiter hatten zunächst Koprolithen von drei archäologischen Fundstätten untersucht: etwa 8000 Jahre alte Überreste aus Hinds Cave im Südwesten der USA, 1400 Jahre alte Reste aus einer Höhle in Rio Zape in Mexiko sowie den 1600 Jahre alten Darminhalt einer Mumie aus Caserones im Norden von Chile. Mit Hilfe von DNA-Untersuchungen bestimmten die Forscher, aus welchen Bakterien die Darmflora der Menschen zu Lebzeiten zusammengesetzt war. Sie verglichen dies dann mit der Darmflora heute lebender Menschen und mit Bakterien-Gemeinschaften aus anderen Umgebungen.
Die Bakterien-Zusammensetzung in den Rio-Zape-Proben ähnele am ehesten der von Kindern aus dem heutigen ländlichen Afrika, berichten die Forscher. Sie fanden in einer dieser Probe Spuren eines bestimmten Bifidobakteriums, das fast ausschließlich bei gestillten Kindern zu finden ist. Daraus schließen die Wissenschaftler, dass der Koprolith von einem Kind stammt. Außerdem entdeckten sie viele Bakterien der Gattung Prevotella, die sich vor allem bei einer kohlenhydratreichen Kost im Darm ansiedeln. In den Proben aus den beiden anderen Fundstätten fanden die Forscher keine Ähnlichkeit mit einer menschlichen Darmflora, wie sie heute bekannt ist. Ein Teil der Koprolithen aus dem Darm der Mumie enthielt eine Bakterien-Gemeinschaft, die aus Kompost bekannt ist.
Anschließend analysierten die Forscher bereits vorhandene Daten zur Darmflora der Gletschermumie «Ötzi» und eines österreichischen Soldaten, dessen Leiche fast 100 Jahre in einem Gletscher gelegen hatte. Auch deren Darmflora ähnelte am ehesten der afrikanischer Kinder vom Land, berichten die Wissenschaftler. Ähnlichkeiten mit modernen, erwachsenen US-Amerikanern fanden sie hier ebenfalls nicht.
«Diese Ergebnisse lassen darauf schließen, dass die moderne kosmopolitische Lebensweise die Darmflora des Menschen dramatisch verändert hat», erläutert Hauptautor Cecil Lewis. Es sei heute akzeptiert, dass Antibiotika und eine verbesserte Hygiene viele Vorteile mit sich brächten, aber dies geschehe nicht ohne Folgen. Indem das ursprünglich Verhältnis des Menschen zu seinen Mikroben verändert werde, werde zum Beispiel auch die Entwicklung unseres Immunsystems beeinflusst. Die Autoren der Studie weisen in diesem Zusammenhang auf eine Theorie hin, nach der diese Veränderungen einen Anstieg von Autoimmun- und anderen Erkrankungen zur Folge haben.
13.12.2012 l dpa
Foto: Fotolia/ggw